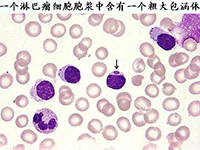
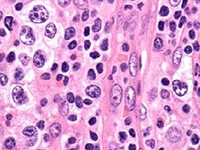

- 霍奇金淋巴瘤的医学治疗
-
-
淋巴瘤是现今世界上比较常见的肿瘤之一,恶性淋巴瘤是淋巴瘤的一种,多发于青壮年。恶性淋巴瘤是发生于网状内皮系统的恶性肿瘤 , 恶性淋巴瘤分为霍奇金病 (HD) 和非霍奇金淋巴瘤 (NHL) 两大类……在[详细]
2016-04-20 14:49
- 非何杰金氏淋巴瘤的治疗
-
-
淋巴瘤是威胁人类健康的一大杀手,淋巴瘤优良恶性之分,良性的淋巴瘤对人体的伤害不是很大,但是恶性的淋巴瘤,对人体的伤害是很大的,若是不及时的治疗是会威胁道患者的生命的。非何杰金氏淋巴瘤就是一种很常见的恶[详细]
2016-04-20 14:49
- 常见的治疗淋巴肿瘤的方法
-
-
在市面上,大大小小的肿瘤医院和诊所很多,当人们患淋巴肿瘤后,也就不知道该如何选择。加上由于淋巴肿瘤的治疗周期比较长,因此专家建议要去专业的肿瘤医院。淋巴瘤具有高度异质性,故治疗上也差别很大,不同病理类[详细]
2016-04-20 14:49
- 淋巴管瘤的治疗原则
-
-
淋巴管瘤是胚胎发育过程中某些部位的原始淋巴囊与淋巴系统隔绝后所发生的肿瘤样畸形,它是先天性的良性错构瘤。对于淋巴管瘤的治疗主要是以手术治疗为主,那么你知道淋巴管瘤的治疗原则有哪些吗?淋巴管瘤的治疗原则[详细]
2016-04-20 14:49
- 淋巴肿瘤疾病的治疗偏方有什么
-
-
淋巴肿瘤是非常严重的疾病,这样的疾病一旦发生不太好康复,所以对于淋巴肿瘤疾病我们需要重视做好科学的治疗,这样才能够早一些康复,减少一些不必要的麻烦,下面就请小编来介绍淋巴肿瘤疾病的治疗偏方有什么?淋巴[详细]
2016-04-20 14:26
- 淋巴肿瘤疾病的早期治疗
-
-
对于淋巴肿瘤这样的疾病我们只有及时发现及时治疗,才能够减少一些不必要的危害出现,也才能够更加有利于疾病得到快速缓解,淋巴肿瘤这样的疾病需要我们积极正确做好治疗,下面来了解淋巴肿瘤疾...[详细]
2016-04-15 15:26
- 恶性淋巴瘤的规范治疗方法
-
-
淋巴肿瘤是现今世界比较常见的肿瘤之一,恶性淋巴肿瘤是淋巴肿瘤的一种,恶性淋巴瘤是淋巴结和结外部位淋巴组织的免疫细胞肿瘤,来源于淋巴细胞或组织细胞的恶变。在我国恶性淋巴瘤虽相对少见,...[详细]
2016-04-15 15:04
- 淋巴瘤化疗的副作用有哪些
-
-
淋巴瘤是现今世界上比较常见的肿瘤之一,它的发病原因和发病的机制目前尚不清楚,在我们国家,近几年来淋巴瘤患者在不断的增加。淋巴瘤的治疗方法有很多,化疗是其中的一种,淋巴瘤患者在化疗时...[详细]
2016-04-13 19:49
- 五大恶性淋巴瘤的治疗方法
-
-
恶性淋巴瘤的治疗方法是什么?恶性淋巴瘤的出现也是给很多人的健康带来很大的危害,对恶性淋巴瘤的治疗方法也是都关注的,下面就介绍一下恶性淋巴瘤的治疗方法。一、手术治疗在结内恶性淋巴瘤患...[详细]
2016-04-13 16:41
- 淋巴肿瘤疾病中医治疗方法
-
-
淋巴肿瘤疾病发生之后我们需要及早做好治疗,在患病的第一时间就应该做好积极的治疗,抓住最佳时机,避免带去太多的健康危害,一起来了解淋巴肿瘤疾病中医治疗方法有什么?希望小编的介绍能够给...[详细]
2016-04-13 16:40
- 晚期淋巴肿瘤该怎样治疗
-
-
如果淋巴肿瘤已经到了晚期,那么治疗的效果已经不是很理想了。治疗的目地就是延长病人的生存周期及提高生活质量。那么,晚期淋巴肿瘤的治疗方法有哪些呢?下面为大家详细介绍。1、手术姑息性切...[详细]
2016-04-13 16:40
- 热门阅读
- 热点排行
免费提问